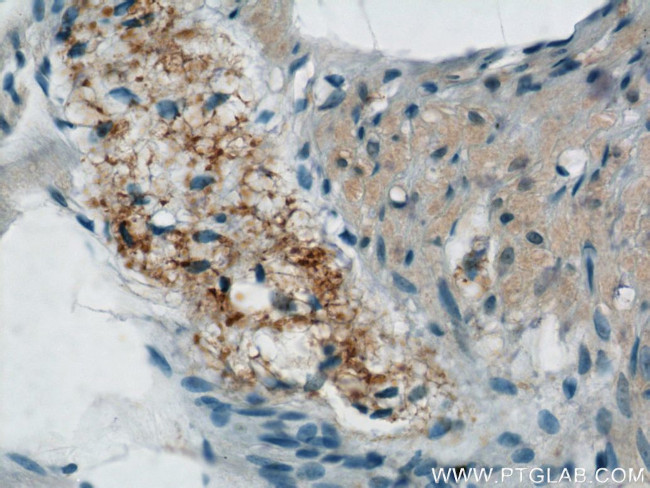
NMU Antibody in Immunohistochemistry (Paraffin) (IHC (P))

Search
Proteintech
NMU Polyclonal Antibody
{{$productOrderCtrl.translations['antibody.pdp.commerceCard.promotion.promotions']}}
{{$productOrderCtrl.translations['antibody.pdp.commerceCard.promotion.viewpromo']}}
{{$productOrderCtrl.translations['antibody.pdp.commerceCard.promotion.promocode']}}: {{promo.promoCode}} {{promo.promoTitle}} {{promo.promoDescription}}. {{$productOrderCtrl.translations['antibody.pdp.commerceCard.promotion.learnmore']}}
产品信息
24862-1-AP
种属反应
宿主/亚型
分类
类型
抗原
偶联物
形式
浓度
规格
纯化类型
保存液
内含物
保存条件
运输条件
产品详细信息
Immunogen sequence: MLRTESCRP RSPAGQVAAA SPLLLLLLLL AWCAGACRGA PILPQGLQPE QQLQLWNEID DTCSSFLSID SQPQASNALE ELCFMIMGML PKPQEQDEKD NTKRFLFHYS KTQKLGKSNV VSSVVHPLLQ LVPHLHERRM KRFRVDEEFQ SPFASQSRGY FLFRPRNGRR SAGFI (1-174 aa encoded by BC012908)
靶标信息
This gene encodes a member of the neuromedin family of neuropeptides. The encoded protein is a precursor that is proteolytically processed to generate a biologically active neuropeptide that plays a role in pain, stress, immune-mediated inflammatory diseases and feeding regulation. Increased expression of this gene was observed in renal, pancreatic and lung cancers. Alternative splicing results in multiple transcript variants encoding different isoforms. Some of these isoforms may undergo similar processing to generate the mature peptide.
仅用于科研。不用于诊断过程。未经明确授权不得转售。
生物信息学
蛋白别名: neuromedin U precursor-related peptide/neuromedin U preproprotein; Neuromedin-U; NmU 25; prepro-NMU
基因别名: NMU
UniProt ID: (Human) P48645
Entrez Gene ID: (Human) 10874